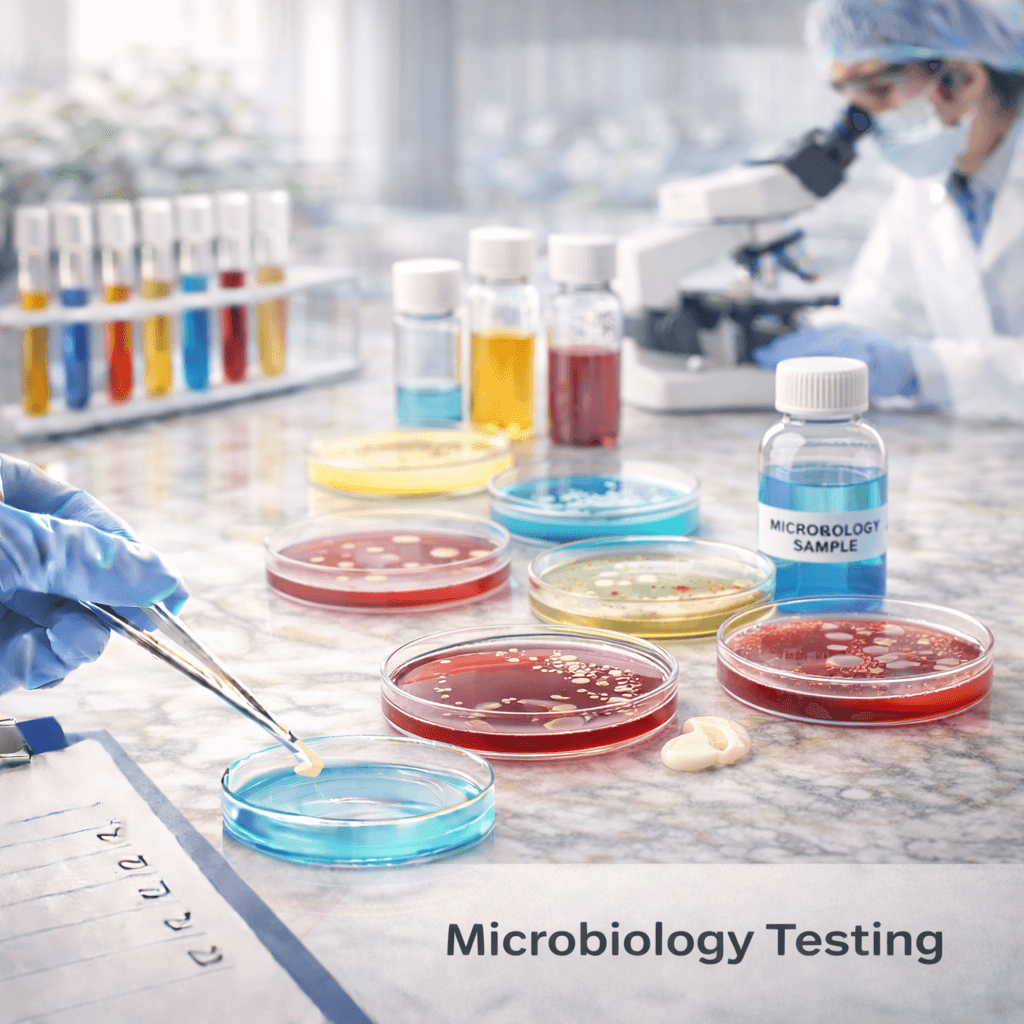

Cosmetics Testing
Our cosmetics and personal care testing services are designed to help brands ensure product safety, stability, and compliance throughout the product lifecycle. We support manufacturers from product development through commercialization with scientifically sound laboratory testing.
ANALYZETESTING LABS offers microbiology, analytical chemistry, and in-package stability testing performed in ISO/IEC 17025 accredited laboratories. Our reliable data helps cosmetic brands meet regulatory expectations and maintain consistent product quality in global markets.
Microbiology Testing
ANALYZETESTING LABS provides microbiology testing to detect and monitor microorganisms that may impact product safety and quality. Our accredited methods support food safety, quality assurance, and regulatory compliance programs.

Analytical Chemistry
Our analytical chemistry services deliver precise chemical analysis to support product quality, safety, and compliance. We provide reliable data using validated methods to support regulatory submissions and quality programs.

In-Package Stability Testing
ANALYZETESTING LABS offers in-package stability testing to evaluate product performance over time. Our testing helps manufacturers assess shelf life, packaging integrity, and product consistency under real-world conditions.
ANALYZETESTING LABS
So The World Can Trust In What It Consumes
analyzetestinglabs partners with customers to deliver innovative scientific solutions and expertise in support of the food & beverage, cosmetic, OTC, supplements, and other regulated industries.
